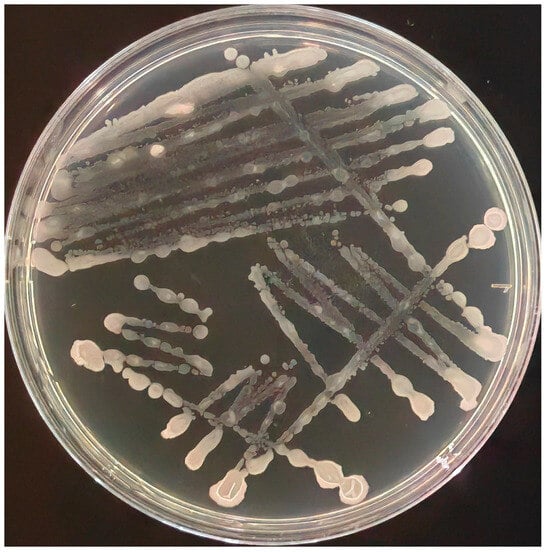

マイストア
変更
お店で受け取る
(送料無料)
配送する
納期目安:
2025.09.24 21:57頃のお届け予定です。
決済方法が、クレジット、代金引換の場合に限ります。その他の決済方法の場合はこちらをご確認ください。
※土・日・祝日の注文の場合や在庫状況によって、商品のお届けにお時間をいただく場合がございます。
洋書 bacillus subtilis Microscope World Blog: Bacillus Subtilis under the Microscopeの詳細情報
Microscope World Blog: Bacillus Subtilis under the Microscope。Biological Characterization and Whole-Genome Analysis of。1-1.png。専門書bacillus subtilisに関する基本知識を習得することができます。今は、日本では手に入りません。Products。代謝、構造と生理、遺伝子構造や輸送システムなどについて記載されています。Hussein Chalayan NaiPublishers 作品集(2005)。【超レア】counterpoint。#bacillus subtilis#バチルス#バチラス#サブチリス#production #commercial product#gram-positive bacteria#chromosome #transcription#bacteriophages
ベストセラーランキングです
近くの売り場の商品
カスタマーレビュー
オススメ度 4.5点
現在、4335件のレビューが投稿されています。